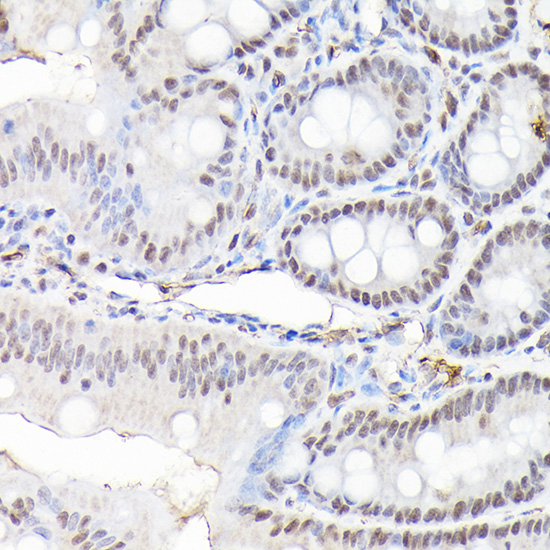

Product Name :
CTCF polyclonal antibody Background :
This gene is a member of the BORIS + CTCF gene family and encodes a transcriptional regulator protein with 11 highly conserved zinc finger (ZF) domains. This nuclear protein is able to use different combinations of the ZF domains to bind different DNA target sequences and proteins. Depending upon the context of the site, the protein can bind a histone acetyltransferase (HAT)-containing complex and function as a transcriptional activator or bind a histone deacetylase (HDAC)-containing complex and function as a transcriptional repressor. If the protein is bound to a transcriptional insulator element, it can block communication between enhancers and upstream promoters, thereby regulating imprinted expression. Mutations in this gene have been associated with invasive breast cancers, prostate cancers, and Wilms' tumors. Alternatively spliced transcript variants encoding different isoforms have been found for this gene. Product :
1mg/ml in PBS with 0.02% sodium azide, 50% glycerol, pH7.2 Storage&Stability :
Store at 4°C short term. Aliquot and store at -20°C long term. Avoid freeze-thaw cycles. Specificity :
Polyclonal Antibodies Immunogen :
Recombinant fusion protein of human CTCF(NP_006556.1). Conjugate :
Unconjugated Modification :
Unmodification
CTCF polyclonal antibody Background :
This gene is a member of the BORIS + CTCF gene family and encodes a transcriptional regulator protein with 11 highly conserved zinc finger (ZF) domains. This nuclear protein is able to use different combinations of the ZF domains to bind different DNA target sequences and proteins. Depending upon the context of the site, the protein can bind a histone acetyltransferase (HAT)-containing complex and function as a transcriptional activator or bind a histone deacetylase (HDAC)-containing complex and function as a transcriptional repressor. If the protein is bound to a transcriptional insulator element, it can block communication between enhancers and upstream promoters, thereby regulating imprinted expression. Mutations in this gene have been associated with invasive breast cancers, prostate cancers, and Wilms' tumors. Alternatively spliced transcript variants encoding different isoforms have been found for this gene. Product :
1mg/ml in PBS with 0.02% sodium azide, 50% glycerol, pH7.2 Storage&Stability :
Store at 4°C short term. Aliquot and store at -20°C long term. Avoid freeze-thaw cycles. Specificity :
Polyclonal Antibodies Immunogen :
Recombinant fusion protein of human CTCF(NP_006556.1). Conjugate :
Unconjugated Modification :
Unmodification
-
 Western blot analysis of extracts of 293T cells, using CTCF antibody at 1:1000 dilution.
Western blot analysis of extracts of 293T cells, using CTCF antibody at 1:1000 dilution.
Secondary antibody: HRP Goat Anti-Rabbit IgG at 1:10000 dilution.
Lysates/proteins: 25ug per lane.
Blocking buffer: 3% nonfat dry milk in TBST.
Detection: ECL Basic Kit .
Exposure time: 5s. -
 Immunohistochemistry of paraffin-embedded human lung cancer using CTCF Rabbit pAb at dilution of 1:100 .Perform high pressure antigen retrieval with 10 mM citrate buffer pH 6.0 before commencing with IHC staining protocol.
Immunohistochemistry of paraffin-embedded human lung cancer using CTCF Rabbit pAb at dilution of 1:100 .Perform high pressure antigen retrieval with 10 mM citrate buffer pH 6.0 before commencing with IHC staining protocol. -
 Immunohistochemistry of paraffin-embedded human lung cancer using CTCF Rabbit pAb at dilution of 1:100 .Perform high pressure antigen retrieval with 10 mM citrate buffer pH 6.0 before commencing with IHC staining protocol.
Immunohistochemistry of paraffin-embedded human lung cancer using CTCF Rabbit pAb at dilution of 1:100 .Perform high pressure antigen retrieval with 10 mM citrate buffer pH 6.0 before commencing with IHC staining protocol. -
Immunohistochemistry of paraffin-embedded human lung cancer using CTCF Rabbit pAb at dilution of 1:100 .Perform high pressure antigen retrieval with 10 mM citrate buffer pH 6.0 before commencing with IHC staining protocol.
Immunohistochemistry of paraffin-embedded human lung cancer using CTCF Rabbit pAb at dilution of 1:100 .Perform high pressure antigen retrieval with 10 mM citrate buffer pH 6.0 before commencing with IHC staining protocol.
Bioworld Biotech only provide peptides for our antibodies and do not provide additional peptide customization services.
Price/Size :
USD 368/1mg/vial
Tips:
For phospho antibody, we provide phospho peptide(0.5mg) and non-phospho peptide(0.5mg).Describe :
Blocking peptides are peptides that bind specifically to the target antibody and block antibody binding. These peptide usually contains the epitope recognized by the antibody. Antibodies bound to the blocking peptide no longer bind to the epitope on the target protein. This mechanism is useful when non-specific binding is an issue, for example, in Western blotting (WB) and Immunohistochemistry (IHC). By comparing the staining from the blocked antibody versus the antibody alone, one can see which staining is specific; Specific binding will be absent from the western blot or IHC performed with the neutralized antibody.Formula:
Synthetic peptide was lyophilized with 100% acetonitrile and is supplied as a powder. Reconstitute with 0.1 ml DI water for a final concentration of 10 mg/ml.The purity is >90%,tested by HPLC and MS.
Storage:
The freeze-dried powder is more stable. For short time at 2-8°C. For long term storage store at -20°C.
Note :
This product is for research use only (RUO only). Not for use in diagnostic or therapeutic procedures.
 CTCF polyclonal antibody
CTCF polyclonal antibody  Datasheet
Datasheet COA
COA MSDS
MSDS SHIP
SHIP